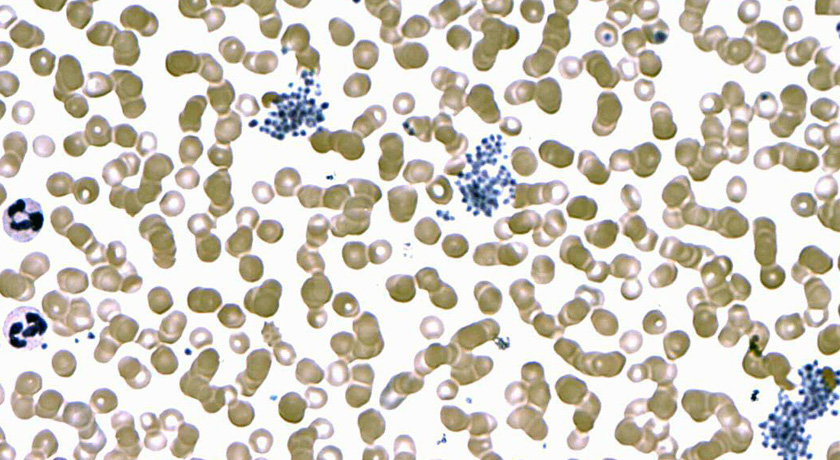
Plasmodium falciparum

Malaria parasite’s invasion of blood cells tweezed apart
With laser-based tweezers, scientists can yank around Plasmodium falciparum cells (purple) and measure the strength of their interactions with red blood cells (brown).
Dr. Osaro Erhabor/Wikimedia Commons (CC BY-SA 3.0)






